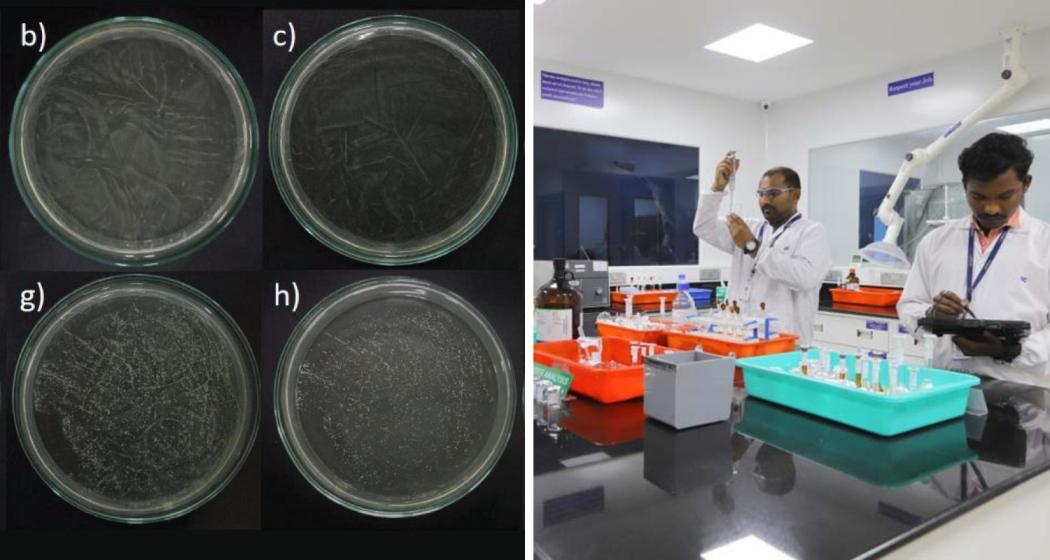
thumbnail image

Researchers at IIT-Madras and the ICMR–National Institute for Research in Reproductive and Child Health (ICMR-NIRRCH) have unveiled a pioneering approach to tackle systemic fungal infections caused by Candida albicans (CAL), a pathogen responsible for high mortality worldwide. Their study, published in Cell Communication and Signaling, combines computational modelling with experimental validation to reveal metabolic vulnerabilities in the fungus that could transform antifungal drug development.
Systemic candidiasis, which can spread to the bloodstream and vital organs, has a mortality rate of up to 63.6 per cent in severe cases. India alone reports around 4.7 lakh invasive cases annually, while globally, infections exceed 1.5 million with nearly one million deaths.
The researchers integrated the CAL model iRV781 with the human metabolic framework Recon3D to create a host–fungal metabolic map. “This allowed us to simulate how the pathogen behaves inside the host and identify metabolic weak points that conventional laboratory methods often miss. One critical discovery was the role of arginine metabolism in fungal virulence. The study identified ALT1, an enzyme acting as a metabolic bottleneck,” said one of the researchers.
Also read: IIT Indore's new device generates electricity from evaporation
Laboratory and mouse model experiments confirmed that disabling ALT1 drastically reduces the fungus’s ability to cause infection. “This work opens doors to diversifying antifungal drugs,” noted Prof. Karthik Raman of the Centre for Integrative Biology and Systems Medicine (IBSE), IIT-Madras, who led the research. “Our approach addresses the limitations of existing therapies, which often lose effectiveness due to rising drug resistance.”
Traditional drug discovery often relies on slow trial-and-error screening. By contrast, this integrated modelling enables direct identification of vulnerabilities, potentially bypassing resistance mechanisms. “The integration of CAL and Recon3D models enabled us to capture pathogen responses during infection and uncover vulnerabilities overlooked by standard methods,” said Dr. Susan Thomas, Principal Investigator at ICMR-NIRRCH.
While preliminary findings have been validated in laboratory and animal models, further mechanistic studies are planned. The team intends to collaborate with clinical partners to test the approach on patient samples and engage industry stakeholders to translate these insights into practical antifungal treatments.